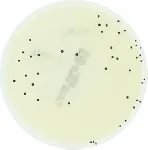
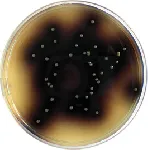
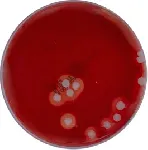
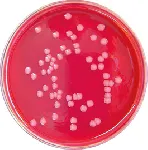
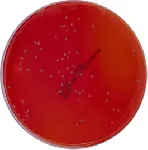
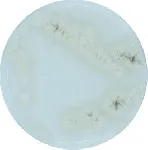
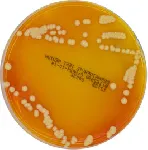
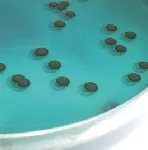
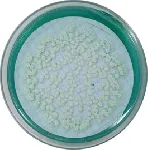
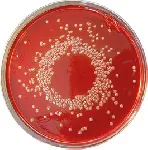
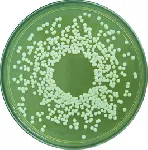
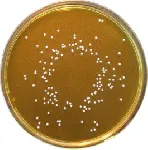
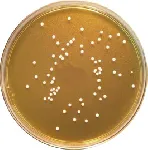
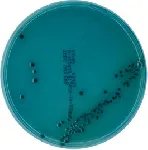
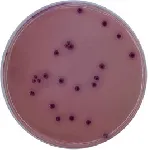

Filter by type
All
Acetamide medium
Algae Agar
Algae Broth
Antibiotic Medium A pH 6,6 (Eur. Pharm.)
Antibiotic Medium A pH 7,9 (Eur. Pharm.)
Antibiotic Medium B (Eur. Pharm.)
Antibiotic Medium C (Eur. Pharm.)
Antibiotic Medium E (Eur. Pharm.)
Antibiotic Medium F (Eur. Pharm.)
Antibiotic Medium No. 3
Antibiotic Medium No. 8
APT Agar
Arginine glucose Agar
Asparagine Broth
Azide Dextrose Broth (Rothe)
Azide Ethyl Violet Broth (EVA Broth)
Bacillus cereus Agar
Bacillus cereus Selective Agar
Baird Parker Agar Base
Baird Parker RPF Agar
BAT Agar
BAT Broth
BCYE Legionella Agar Base
BCYE Legionella without Cysteine
BCYE+AB Legionella Selective Agar (ISO)
Beerens Cosmetic Diluent
Bile Esculin Azide Agar
Bile Esculin Modified Agar
Blood Agar Base
Blood Agar Base (Columbia)
Blood Agar Base No. 2
Bolton Enrichment Broth Base
Brain Heart Infusion (BHI) Supplemented with SPS (0,05%)
Brain Heart Infusion Agar (BHI Agar)
Brain Heart Infusion Broth (BHI Broth)
Brettanomyces Agar
Brilliant Green Agar (BGA)
Brilliant Green Bile 2% Broth
Brilliant Green Modified Agar
Bryant & Burkey, lactate broth (BBLB)
Buffer Phosphate pH 7,2 (0.05M)
Buffered Peptone Phosphate Water
Buffered Peptone Water (Eur. Pharm.) + 0,1% Histidin + 0,3% Lecithin + 3% Polysorbate 80
Buffered Peptone Water (ISO)
Buffered Peptone Water 0,1% (Eur. Pharm.)
Buffered Peptone Water Modified
Burkholderia cepacia Selective Agar Base (BCSA)
Cary-Blair Transport Medium
Casein Lecithin Polysorbate, Broth base
CCD Modified Agar (Charcoal Cefoperazone Deoxycholate)
Cetrimide Agar (Eur. Pharm.)
Chapman Agar (Mannitol Salt Agar)
Chapman TTC Agar
Chloramphenicol Glucose Agar (CGA)
Chocolate Agar - Supplemented
CLED Agar
Clostridium difficile, Broth
Clostridium perfringens Selective Agar (SPS Agar)
CN Selective Agar
Columbia Agar (Eur. Pharm)
Columbia CNA Agar Base
Cronobacter Selective Broth base (CSB)
Czapek-Dox Agar
D/E Neutralizing Agar Base
D/E Neutralizing Broth Base
Decarboxylase Lysine Broth (Taylor)
Deoxycholate Lactose Agar
Dermatophytes Selective Agar
Dextrose Tryptone Purple Bromcresol Agar
DG 18 Agar
DG 18 Metal Agar
Dichloran Rose Bengal Chloramphenicol Agar
DNase Agar
E. coli Broth (EC Broth)
Endo Agar Base
Endo LES Agar
Enrichment Enterobacteriaceae Broth (EE Broth)
Eosin Methylene Blue Agar (EMB Agar)
Eugon LT Modified, Agar Base
Eugon LT Modified, Broth
Fecal Coliforms Agar (m-FC Agar)
Fluid A
Fluid A 0.1% + buffer
Fluid D
Fluid K
GBS Modified Agar
GC Agar Base
Giolitti-Cantoni Broth
Glucose Bromocresol Purple Agar
Gram Negative Broth (GN Broth)
Haemophilus Test Agar Base (HTM)
HC Agar Base
Hektoen Enteric Agar
HTM Broth
Iron Sulfite Modified Agar
K Agar
Kanamycin Esculin Azide Agar (KAA Agar)
Kanamycin Esculin Azide Broth (KAA Broth)
Kenner Fecal Agar (KF Agar)
King A Agar (P Agar)
King B Agar (F Agar)
Kligler Iron Agar (KIA)
Lactose Broth
Lactose Gelatin Medium
Lactose Sulfite Broth Base
Lauryl Sulfate MUG Broth
LB Agar (Miller)
LB Broth
LB Broth (Lennox)
LB Broth (Miller)
Legionella Acid Buffer Solution pH 2,2
Legionella Selective (GVPC) Agar (ISO)
Legionella Selective (MWY) Agar (ISO) with Anisomycin
Letheen Agar
Letheen Broth
Letheen Modified Agar
Letheen Modified Broth
Letheen Modified Broth (FDA)
Liebermeister & Braveny Agar
Linden Grain Broth
Listeria Enrichment Broth Base (Lovett)
Listeria Enrichment Broth Base (UVM)
Listeria Enrichment Broth Fraser
Löwenstein-Jensen Medium Base
Löwenstein-Jensen Pyruvate Medium
Lysine Agar
Lysine Iron Agar (LIA)
m-CP Agar Base
m-Green Agar
m-Green Broth
m-Lauryl Sulfate Agar
m-TGE
M17 Agar
MacConkey Agar (Eur. Pharm.)
MacConkey Broth
MacConkey Broth (Eur. Pharm.)
MacConkey No.2 Agar
MacConkey Sorbitol Agar (Modified)
Malt Extract Agar (Blakeslee)
Malt Extract Agar No. 1
Malt Extract Agar No. 2
Malt Extract Agar No. 3
Malt Extract Broth No. 1
Malt Extract Broth No. 2
Mannitol Motility Test
Marine Agar
Maximum Recovery Diluent (MRD)
Methyl Red Voges Proskauer Broth (MRVP Broth)
Methyl Red Voges Proskauer Saline Broth
Microbial Content Test Agar
Mineral Modified Glutamate Agar Base
Mineral Modified Glutamate Medium Base
Müller-Kauffmann Tetrathionate Broth Base
Motility Indol Ornithine Fluid Medium (MIO)
Motility Indole Urea
Motility Nitrate Medium
MP Buffer pH= 7,0 Solution + Polysorbate
MRS Agar
MRS Agar (ISO)
MRS Broth
MRS BROTH Non Animal
MRS, Broth (Non porcine origen)
Mueller-Hinton Agar
Mueller-Hinton Blood Agar
Mueller-Hinton Broth
Neutralizing Broth (APHA)
Neutralizing Fluid
Neutralizing Special Broth
Nickerson Agar
Nitrate Broth
Nutrient Agar
Nutrient Agar (APHA, ISO)
Nutrient Agar (ISO)
Nutrient Broth (APHA)
Nutrient Broth (B.Ph.)
Orange Serum Agar
Oxford Agar Base
Oxidation-Fermentation Fluid Medium Base (O/F Medium)
Oxidation-Fermentation Glucose Medium
Palcam Agar Base
Peptone from casein Agar Medium (GA)
Peptone Water, Alkaline
Peptone Water, Alkaline Saline
Peptone Water, Salt
Phenol Red Broth Base
Phenylalanine Agar (PPA)
Phosphate Buffered Saline (PBS) pH 7,2
Plate Count Agar (PCA)
Plate Count Modified Agar
Plate Count Skim Milk Agar
Potato Dextrose Agar (Eur. Pharm.)
Potato Dextrose Broth
Preston Campylobacter Agar Base
Preston Campylobacter Broth Base
Pseudomonas Agar Base (ISO)
Pseudomonas CFC Agar
Purple Broth Base
R2A Agar
Raka Ray Agar
Rappaport Vassiliadis Broth
Rappaport Vassiliadis Modified SemiSolid Medium Base
Rappaport Vassiliadis Salmonella Enrichment Broth
Reinforced Clostridial Agar
Reinforced Clostridial Medium (Eur. Pharm.)
Reinforced Clostridial Medium Differential (DRCM)
Rhamnose Broth
Ringer, powder
Rose Bengal Chloramphenicol Agar
Sabouraud Broth (Eur. Pharm.)
Sabouraud Chloramphenicol Agar
Sabouraud Chloramphenicol Modified Agar
Sabouraud Chloramphenicol Penase Agar
Sabouraud Dextrose Agar
Sabouraud Oxytetracycline Agar (OGYEA)
Sabouraud TLHTh Agar
Saline Solution
Salmonella Shigella Agar (SS Agar)
Schaedler Agar
Scholten's Agar modified
Scholten's Broth modified
Selenite Broth Base
Selenite Cystine Broth Base
Shigella Broth
SIM Medium
Simmons Citrate Agar
Slanetz Bartley Agar
Sorbitol Bile Broth
Sporulating Agar
Stuart Ringertz Transport Medium
Sugar Free Agar
TAT (Tryptone - Azolectin- Tween®)
TCBS Agar
Terrific Broth
Tetrathionate Bile Brilliant Green Broth Base
Thayer Martin VCNT Agar
Thioglycollate Broth
Thioglycollate Fluid Medium
Thioglycollate Fluid Medium Penase
Todd-Hewitt Broth
TOS Propionate agar base
Tributyrin Agar
Triple Sugar Iron Agar (TSI Agar)
Tryptic Soy Agar (TSA) (Eur. Pharm.)
Tryptic Soy Broth (TSB) (Eur. Pharm.)
Tryptic Soy Broth Modified
Tryptic Soy Broth without Dextrose
Tryptone Bile Agar
Tryptone Glucose Extract Agar (TGE Agar )
Tryptone Sulfite Neomycin Agar (TSN Agar)
Tryptone Water
Tryptone Yeast Extract Agar
Tryptophan Broth
Tryptose Lauryl Sulfate Broth
Tryptose Lauryl Sulfate Mannitol Tryptophan Broth
Tryptose Lauryl Sulfate Modified Base Broth (mLST)
Tryptose Sulfite Cycloserine Agar (TSC Agar)
Universal Beer Agar (UBA)
Urea Agar Base
Urea Broth Base
Violet Red Bile Dextrose Agar (VRBD AGAR) (Eur. Pharm.)
Violet Red Bile Lactose Agar (VRBL Agar)
Violet Red Bile Lactose Dextrose Agar
Vogel Johnson Agar (VJ Agar)
WL Nutrient Agar
Wort Agar
Wort Broth
XLT4 Agar Base
Xylose Fermentation Broth
Xylose Lysine Deoxycholate Agar (XLD Agar) (Eur. Pharm.)
Xylose Lysine Deoxycholate Modified Agar
Yeast Extract Peptone Dextrose Broth (YEPD Broth)
Yeast Malt Agar (YM Agar)
Yeast Malt Broth
Yeast Starch Glucose Agar
Yeast Starch Glucose Broth (YSG)
Yersinia CIN Agar Base

 Rest of the World
Rest of the World